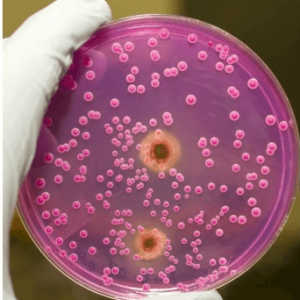
image
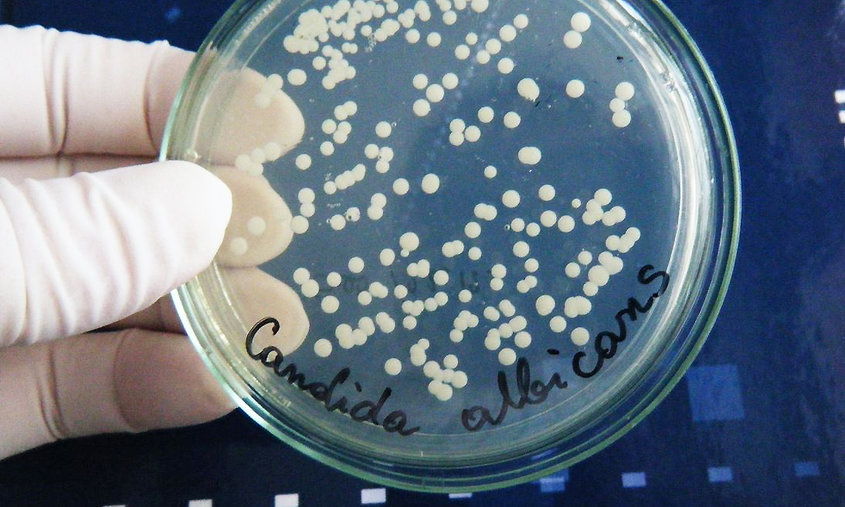
image

При заболевании молочницы врач практически всегда назначает пройти бактериологическое обследование мазка из влагалища. Бактериологический мазок – это достаточно простой анализ, с помощью которого можно определить какие именно микробы (флора) и в каком именно количестве (что очень важно), находятся во влагалище, матке, канале шейки и в мочеиспускательном канале.
Как подготовиться к взятию мазка из влагалища?
Для этого необходимо:
- За один-два дня до обследования необходимо отказаться от половых контактов.
- За 2-3 дня до обследования откажитесь от средств интимной гигиены и спринцеваний.
- За неделю до обследования нельзя принимать лекарственные средства в виде вагинальных таблеток, свечей и спреев.
- Гигиену перед обследованием провести только водой, без моющих средств. Утром не подмываться вообще.
- Желательно не мочиться за два-три часа до обследования.
Бактериологический мазок из влагалища берется в первые дни после окончания менструации или перед началом. Если в назначенный день у вас началась менструация, свяжитесь с врачом и перенесите визит.
Бактериологический мазок из влагалища
Для проведения бактериологического анализа берется небольшое количество слизи и выделений из области влагалища, мочеиспускательного канала и шейки матки. Этот анализ обычно берется при каждом посещении гинеколога.
Первый этап – гинекологический осмотр, во время которого гинеколог вводит во влагалище металлический или пластиковый расширитель, подобранный по размеру пациентки в каждом отдельном случае. Во время процедуры необходимо расслабиться, дышать ровно и глубоко – это избавит от неприятных ощущений.
Второй этап – после осмотра стенок влагалища и шейки матки, врач, с помощью стерильных тампонов собирает небольшое количество выделений из влагалища, матки, канала шейки и мочеиспускательного канала. Данная процедура практически безболезненна.
Третий этап – собранные с помощью тампона выделения наносятся врачом на специальные стекла, которые отправляются в лабораторию, где их окрашивают и изучают под микроскопом. Результаты могут быть готовы через несколько часов.
Взятие мазка из влагалища переносится хорошо без осложнений. Лишь иногда после осмотра и взятия мазка могут возникнуть незначительные боли внизу живота или скудные выделения, которые исчезают через несколько часов после взятия. После такого осмотра не нужно соблюдать какой-то режим и отказываться от половых контактов. Если после взятия мазка в течение нескольких дней появились кровяные выделения необходимо обратиться к врачу.
Во время беременности бактериологический анализ рекомендуется пройти не менее трех раз в профилактических целях. Второй и третий мазок берут в середине и в конце беременности. Гинекологический осмотр совершенно безвреден для плода и беременной женщины.
Выявление болезней с помощью мазка и при осмотре
Мазок из влагалища на определение микрофлоры диагностирует такие заболевания как: цервицит, вагинит, молочница (кандидоз), бактериальный вагиноз, а так же ЗППП (заболевания передающиеся половым путем) – гонорею, хламидиоз, уреаплазмоз и трихомониаз. По усмотрению врача данное исследование дополняется исследованием культуральным – это количественное определение содержания микробов в половых путях и методом ПЦР-диагностики, который практически безошибочно определяет множественные инфекции, которые передаются половым путем.
Плохой результат мазков – не повод для печали
Плохой анализ не должен пугать пациента. В наше время практически все инфекции хорошо поддаются лечению. Если анализ мазка плохой, в этом случае:
- обратитесь к врачу гинекологу для продолжения обследования;
- если выявлены серьезные отклонения, врач назначит вам лечение;
- до обращения к враче не предпринимайте попыток самолечения;
- не проводите спринцеваний. Спринцевание способно усугубить нарушение микрофлоры и ухудшить показания мазка. Отказ от спринцеваний дает больше шансов на выздоровление.
Воспользуйтесь рекомендациями гинекологов, сделайте правильные выводы и будьте здоровы!
Клинические проявления молочницы сложно спутать с другими заболеваниями. Несмотря на это, диагностика кандидоза проводится в обязательном порядке. Только после сдачи анализов и постановки точного диагноза врач может назначить адекватный курс терапии.
Нужно ли сдавать мазок при молочнице
Самый простой анализ на кандидоз – вагинальный мазок. Это эффективный способ определения разновидности грибковой инфекции и количества патогенных микроорганизмов в микрофлоре влагалища.
Мазок при молочнице обязательно берется у беременных женщин. В этот период их организм подвержен всевозможным инфекциям, а своевременное диагностирование заболевания позволит защитить плод от воздействия грибков кандида.
Кроме того, исследование мазка помогает установить точный диагноз. Существует несколько видов грибков, и только определив их разновидность, можно контролировать процесс терапии кандидоза. Эта информация крайне важна при хронической рецидивирующей форме болезни, когда возбудитель инфекции вырабатывает устойчивость к определенным медикаментам.
Обследование помогает узнать о наличии сопутствующих заболеваний со слабовыраженной клинической картиной.
Анализ делают и при профилактическом осмотре. За счет этого становится возможной диагностика молочницы у женщин на ранней стадии развития патологии. В домашних условиях можно определить недуг с помощью теста на молочницу.
Как готовиться к сдаче мазка
К любым лабораторным исследованиям нужно заблаговременно подготавливаться, и анализ на молочницу не является исключением.
За неделю до сдачи мазка нужно отказаться от специальных процедур, очищающих слизистую влагалища. К ним можно отнести спринцевания и подмывания лекарственными или народными средствами. В данной ситуации подойдет спринцевание содой, которое будет полезно и при подтверждении молочницы.
Чтобы посев на кандиду показал правильные результаты, за несколько дней до проведения анализа рекомендуется отказаться от интимной близости.
С целью изучения выделений из половых органов берется мазок. Такую процедуру проводят на гинекологическом кресле с использованием специальных палочек или тампонов. Следует позаботиться о том, чтобы в наличии оказался осмотровый набор, нужный для этих манипуляций.
Что определяют в лаборатории и для чего
Только полноценное обследование позволяет распознать возбудителя молочницы и выбрать оптимальный курс терапии. Лабораторная диагностика кандидоза включает в себя несколько методов:
- микроскопия биологического отделяемого из влагалища;
- посев на грибы рода кандида;
- ПЦР;
- ИФА.
Все анализы при молочнице выполняют определенные функции. По этой причине проводятся они в комплексе. При тщательном обследовании удается определить стадию болезни и подобрать медикаменты, полностью исключающие риск рецидивов.
Микроскопия мазка позволяет узнать о количестве патогенов, спровоцировавших развитие кандидоза. Посев на флору не только выявляет наличие псевдомицелия, но и определяет чувствительность этого организма к различным антимикотическим препаратам. Проведение данного анализа крайне важно при хронических формах кандидоза вульвы.
С целью распознавания ДНК вируса и проверки на наличие антител к возбудителю инфекции в крови проводят диагностику методами ПЦР и ИФА. Только после получения результатов всех исследований можно приступать к лечению молочницы. Без этих данных терапия далеко не всегда оказывается эффективной.
Тест на молочницу в домашних условиях
Тест на молочницу под названием Frautest Candida появился на аптечных прилавках совсем недавно. Как утверждает производитель, с его помощью выявить грибковую инфекцию в организме женщин можно без труда в домашних условиях. Принцип действия заключается в сопоставлении антигена и антитела. На латексную полоску нанесены антитела к патогенному микроорганизму, которые приобретают синий окрас при взаимодействии с грибком кандида.
Точность этого теста достигает 90 %, но серьезных исследований, подтверждающих это, учеными проведено не было.
Второй способ диагностики кандидоза с помощью экспресс-теста – использование чувствительной прокладки (к примеру, Ал-Реках), которая прикрепляется к нижнему белью, а спустя определенное время помещается в специальный футляр. В результате проведения этой процедуры удается узнать об изменениях микрофлоры.
Стоит отметить, что даже если такие анализы на молочницу указали на наличие грибковой инфекции, но никаких клинических проявлений болезни не отмечается, женщина считается здоровой и не нуждается в лечении.
Многих женщин волнует вопрос, может ли болеть живот при молочнице. В целом, не всегда данный симптом будет свидетельствовать о наличии патологии, поэтому стоит прочитать дополнительную информацию по данной теме и обратиться за консультацией к специалисту.
Когда и у кого берут кровь при кандидозе
На развитие молочницы, как правило, указывают характерные симптомы, но в некоторых случаях они проявляются только у одного их половых партнеров. При этом нужно проводить комплексное обследование, чтобы выявить кандидоз.
Анализ крови способен указать на наличие грибковой инфекции даже в тех случаях, когда исследования мазка и посева не дали положительных результатов. Реакция ПЦР и УФА позволяют узнать о наличии антител к Candida albicans.
Помимо этого, анализ крови проводится при трудностях с определением причины активизации патогенных микроорганизмов. Таким образом удается выявить развитие инфекционного заболевания, сахарный диабет и ряд других проблем.

Мазок на заболевания урогенитальной сферы — один из самых распространенных и информативных методов анализа в современной медицине. С его помощью можно выявить не только банальные воспаления, но и предупредить развитие онкологических заболеваний. Несмотря на надежность и доступность метода, не все женщины осознают необходимость регулярного посещения гинеколога и сдачи анализов и нередко обращаются к врачу только в запущенных случаях.
Показания к назначению анализа мазка у женщин
Каждая женщина хоть раз в своей жизни, посещая гинеколога, сдавала мазок на микрофлору или скрытые инфекции. Мазок берется со стенок влагалища, цервикального канала и шейки матки. В лабораторных условиях проводится микроскопическое исследование клеток, содержащихся в биологическом материале. Такой анализ позволяет оценить состояние эпителиальных клеток матки и влагалища, выявить патогенные микроорганизмы и заболевания, передающиеся половым путем. Мазок желательно сдавать регулярно, раз в год, даже если у женщины нет видимых поводов для беспокойства, поскольку многие инфекции в течение длительного времени могут не вызывать никаких симптомов.
В обязательном порядке назначается мазок в тех случаях, когда женщина жалуется на зуд и жжение в области половых органов, необычные выделения из них, внезапную боль внизу живота. Как правило, эти признаки указывают на наличие какого-либо заболевания, диагностировать которое можно только с помощью анализа мазка. Кроме того, желательно провести исследование биоматериала в том случае, если у женщины произошел незащищенный контакт с малоизвестным ей партнером и есть риск заразиться инфекционным заболеванием, передающимся половым путем.
Также врач-гинеколог назначает обязательную сдачу анализа мазка женщинам, планирующим беременность, готовящимся к ЭКО или другим процедурам искусственного оплодотворения (ВРТ). Женщинам, ожидающим ребенка, анализ мазка проводится трижды на всем протяжении срока, поскольку инфекции способны передаваться от матери к ребенку, осложнять роды или вызывать выкидыш.
В гинекологии существует несколько типов анализа мазка в зависимости от вида исследования.
Появление на питательном субстрате колоний микроорганизмов говорит о наличии заболевания. Метод посева также используется для определения стратегии лечения, поскольку во время созревания колонии можно выяснить, к воздействию каких групп антибиотиков она особенно неустойчива.
- Мазок на скрытые инфекции . К скрытым инфекциям относят группу болезней, которые могут бессимптомно протекать на протяжении нескольких месяцев или даже лет, вызывая осложнения, а некоторых случаях — даже бесплодие. На сегодняшний день наиболее достоверным способом выявления скрытых инфекций является исследование мазка при помощи ПЦР (полимеразной цепной реакции). Этот метод используется для диагностики инфекций, не обнаруживаемых в общих мазках. Для проведения анализа берется секрет из шейки матки, влагалища или мочеиспускательного канала и производится многоэтапное повышение концентрации нуклеиновой кислоты и копирование отдельных фрагментов ДНК присутствующих в мазке микроорганизмов. В результате врач может установить видовую и родовую принадлежность всех патогенных бактерий и их способность вызывать развитие заболеваний. В большинстве случаев ПЦР-анализ применятся при подозрении на наличие заболеваний, передающихся половым путем и имеющих на ранних стадиях практически бессимптомное течение. Преимуществами метода являются:
- высокая точность определения возбудителя инфекции;
- возможность определения именно наличия вируса, а не продуктов его жизнедеятельности или распада;
- возможность постановки точного диагноза на основе всего одной клетки микроорганизма.
- Мазок на онкоцитологию, или тест по Папаниколау (пап-тест) , позволяет выявить наличие онкологических заболеваний в шейке матки на ранних стадиях и вовремя начать терапию. Пап-тест определяет большинство воспалительных заболеваний, дисплазию эпителия и злокачественные образования. Сдавать этот мазок рекомендуется ежегодно всем женщинам в возрасте от 21 до 65 лет. В случае если у женщины наблюдаются нарушения менструального цикла, воспалительные процессы цервикального канала, бесплодие, врач назначит мазок на онкоцитологию в обязательном порядке. Также рекомендуется пройти пап-тест при диагностировании диабета, ожирения 2–3 степени, в период планирования беременности, при приеме гормоносодержщих препаратов и наличии в организме вирусов генитального герпеса и папилломы. При анализе мазка можно получить пять типов результата в зависимости от наличия и степени патологии. Первый тип — это отрицательный показатель, говорящий о том, что никаких отклонений от нормы в организме женщины нет, и она полностью здорова. При втором типе присутствует воспалительное заболевание, требующее лечения. Третий тип свидетельствует о наличии в эпителии единичных клеток с аномальным строением ядра. Четвертый тип — подозрение на злокачественное образование или эрозию шейки матки, генитальный герпес, папиллломовирусную инфекцию, паракератоз. Пятый тип — наличие онкологического заболевания, требующего незамедлительного лечения. Следует помнить, что мазок показывает только степень изменения клеток, но не причину, их вызвавшую. Для постановки диагноза необходимы результаты других анализов, включая биопсию, кольпоскопию и гистологическое исследование. Если в мазке будут найдены атипичные клетки, то в заключении будет об этом написано, а также будет указан тип изменений. Если в расшифровке мазка на цитологию нет особых примечаний, это говорит о том, что в ходе исследования никаких патологий обнаружено не было.
При выборе дня для взятия мазка нужно учитывать менструальный цикл. Желательно сдавать анализ перед началом менструации или через несколько дней после ее окончания (оптимальный срок — пятый день), чтобы избежать попадания крови в мазок. Хотя процедура взятия мазка и не слишком сложна, все же необходимо заранее принять некоторые дополнительные меры, чтобы обеспечить чистоту результата. Подготовка к мазку на инфекции у женщин заключается в следующем:
- Не использовать вагинальные свечи, тампоны, мази перед анализом.
- Отказаться от спринцевания.
- При наличии воспалительного заболевания, сопровождающегося обильным выделением секрета необходимо сначала провести лечение и только после полного выздоровления сдавать мазок.
- Воздержаться от половых контактов в течение одного-двух дней до сдачи анализа.
- Не использовать средства интимной гигиены накануне и в день процедуры.
- Воздержаться от опорожнения мочевого пузыря в ближайшее время перед сдачей мазка.
В остальном женщина может вести обычный образ жизни: не требуется ограничений ни по питанию, ни по физической активности.
Взятие у женщины мазка на флору, на скрытые инфекции и на онкоцитологию несколько различается. Во всех случаях перед процедурой женщина проходит общий гинекологический осмотр на кресле с помощью зеркала.
При мазке на флору после визуальной оценки стенок влагалища врач специальным стерильным шпателем осуществляет забор материала из трех участков — влагалища, шейки матки и наружного отверстия мочеиспускательного канала. В некоторых случаях забор производится только с двух первых участков. Взятый шпателем материал равномерно широким мазком распределяется по стерильному предметному стеклу. Нанесение материала каплей, толстым слоем или небольшим мазком считается неправильным, поскольку затрудняет работу врача-лаборанта. При этом материалы из разных участков должны наносится на стекло отдельно друг от друга. С обратной стороны стекла врач делает пометки о месте взятия мазка: U — мочеиспускательный канал, V — влагалище, С — шейка матки. После этого стекло высушивается и направляется в лабораторию на исследование.
При сдаче мазка у женщин на скрытые инфекции и на онкоцитологию забор материала производится специальной щеточкой или с помощью особых стерильных ватных тампонов. Перед взятием материала обязательно удаляют слизь, так как ее наличие может дать ложный результат. Поскольку большинство микроорганизмов являются внутриклеточными паразитами, точное обнаружение их возможно только при исследовании соскоба со стенок половых органов. При анализе на скрытые инфекции материал со щеточки помещают в физраствор, хранящийся в холодильнике. Мазок на онкоцитологию наносят на предметное стекло и высушивают.
Как правило, процедура забора мазка для женщины практически безболезненна. Неудобство может вызывать соприкосновение с гинекологическим зеркалом из-за разницы температур между телом и металлическим инструментом. При взятии материала тампоном или щеточкой с шейки матки может отмечаться незначительное болевое ощущение, которое проходит сразу после окончания манипуляции. Мазок на онкоцитологию иногда способен вызывать незначительные кровянистые выделения в течение двух-трех дней. Если возникают сильные кровотечения, повышение температуры, боли в животе, то необходимо срочно обратиться к гинекологу, поскольку такие симптомы при взятии мазка нормой не являются.
После проведения анализа мазка пациентка получает результаты, которые полностью зависят от типа, назначенного ей исследования.
При расшифровке анализа мазка на флору необходимо знать показатели нормы:
- Плоский эпителий (пл.эп) — у здоровой женщины этот показатель не должен превышать 15 клеток в поле зрения. Большее их количество говорит о воспалительном процессе, а меньшее — о наличии гормональных нарушений.
- Лейкоциты (L) . Нормальное количество во влагалище — не более 10-ти, а в шейке матки не более 30-ти единиц.
- Палочки Дедерлейна , обеспечивающие нормальную микрофлору женских половых органов. В мазке здоровой женщины они должны присутствовать в большом количестве, поскольку их недостаток свидетельствует о нарушенной микрофлоре влагалища.
- Слизь должна присутствовать в мазке в умеренном количестве. Обильные выделения слизи — признак воспаления или инфекции.
- Грибки рода кандида, гонококки, трихомонады в мазке выявляться не должны. Их наличие свидетельствует о заболевании.
Кроме этих показателей в анализе может быть указана одна из четырех степеней чистоты влагалища. Нормальными являются только первая и вторая степень, третья и четвертая являются признаком заболевания половых путей.
Результаты анализа мазка на скрытые инфекции можно получить через 1–2 суток после сдачи. В некоторых случаях они могут быть готовы прямо в день прохождения процедуры. При помощи мазка выявляются следующие инфекции:
- герпес-вирус человека 1 и 2 типов;
- вирус Эпштейна-Барр;
- цитомегаловирус;
- герпес-вирус человека;
- вирус папилломы человека;
- бледная трепонема;
- мобилункус;
- бактероиды;
- гонококк;
- гарднерелла;
- микоплазма;
- уреаплазма;
- хламидии.
Мазок на инфекции в большинстве случаев является достаточно надежной диагностической процедурой. С его помощью можно выявить большинство серьезных заболеваний половой сферы, при этом стоимость анализа является вполне доступной даже в частных клиниках.
Около 75% женщин за свою жизнь хотя бы раз сталкивались с вульвовагинальным кандидозом (молочницей). Заподозрить наличие молочницы женщина может по зуду в половых органах и творожистым белым выделениям из влагалища. Но для подтверждения диагноза потребуется провести бактериологическое исследование урогенитального мазка.
Подготовка к исследованию
Микроскопическое исследование урогенитального мазка включает в себя определение клеточных элементов (лейкоцитов, эпителиальных клеток) и бактериологическое исследование с выявлением бактерий и дрожжевых грибов.
Этот диагностический метод знаком всем женщинам. Тем ни менее не все знают, как правильно подготовится к исследованию. Женщине нужно помнить, что взятие мазка можно проводить лишь спустя двое суток после полового акта, а также проведения диагностических процедур (кольпоскопии, трансвагинального УЗИ).
Во время менструации урогенитальный мазок не отбирают, а значит, придется подождать ее окончания. Оптимально отбирать мазок на пятый-седьмой день по завершению менструации. За два-три часа до манипуляции не рекомендуется мочиться. Накануне манипуляции нельзя спринцеваться, использовать антисептики. Достаточно утром просто подмыться водой и вытереться чистым полотенцем.
Процедура взятия мазка
Далее отобранный материал передается в лабораторию, где лаборант окрашивает одно стеклышко метиленовым синим, а другое — по Граму. Когда стеклышки подсохнут, приступают к их детальному изучению под микроскопом.
Оценка результатов
При микроскопическом исследовании мазка лаборант определяет количество и соотношение микроорганизмов (бактерий, грибов), а также клеточных элементов (лейкоцитов, эпителиальных клеток). Полученные результаты позволят врачу сделать вывод о характере вагинальной микрофлоры, наличии воспалительного процесса.
Какие же показатели являются нормой?
- Лейкоциты — норма во влагалище 0-10 клеток в поле зрения, в шейке матки — 0-30, в уретре — 0-5;
- Эпителий — умеренное количество плоского эпителия;
- Слизь — в умеренном количестве;
- Грамположительные палочки (Гр.+), палочки Додерлайна, лактобациллы — в норме содержатся в большом количестве во влагалище, а вот в шейке матки и уретре отсутствуют;
- Грамотрицательные палочки (Гр.-), гонококки (gn.), трихомонады (trich), хламидии, дрожжевые грибы, а также ключевые клетки — в норме отсутствуют.
Урогенитальный мазок при молочнице
Как известно, кандидоз (молочница) вызывается дрожжевыми грибами рода Candida. О молочнице свидетельствует обнаружение спор и мицелия грибов при микроскопическом исследовании мазка. Также в пользу имеющегося воспалительного процесса свидетельствуют такие изменения в мазке как увеличение количества лейкоцитов, плоского эпителия.
Стоит отметить, что микроскопическое исследование мазка позволяет лишь выявить наличие дрожжеподобных грибов, однако не позволяет определить вид микроорганизма. Получить такую информацию можно с помощью бакпосева мазка.
Бактериальный посев урогенитального мазка
Бактериальный посев мазка представляет собой исследование во время которого взятый материал помещается на специальную питательную среду. В течение нескольких суток происходи активное размножение имеющихся микроорганизмов, в частности грибов.
Бактериальный посев позволяет определить количество дрожжевых грибов. Диагноз молочницы подтверждается при количестве грибов свыше 10 4 КОЕ/мл. Кроме того, проведение бакпосева урогенитального мазка позволяет определить, какой именно вид грибка вызвал кандидоз, а также какие противогрибковые препараты будут наиболее эффективными. Это особенно важно при хроническом кандидозе, когда женщина лечится всевозможными препаратами, но они оказываются неэффективными и недуг возвращается снова и снова.
Для получения достоверных результатов женщине нужно соблюсти правила подготовки к процедуре:
- Забор урогенитального мазка проводится до начала лечения противогрибковыми, антибактериальными лекарствами;
- В течение трех часов до манипуляции рекомендуется воздерживаться от мочеиспускания;
- За двое суток до манипуляции воздержаться от сексуальных контактов;
- В течение двух суток полностью исключить спринцевание, использование вагинальных свечей и мазей;
- Исследование нельзя проходить при менструации, лишь спустя три дня после окончания.
После подтверждения диагноза молочницы врач назначает женщине соответствующее лечение. Спустя четырнадцать дней после завершения курса лечения может потребоваться повторное проведение бактериального посева урогенитального мазка. Результаты повторного исследования позволят оценить насколько эффективной оказалась назначенная схема лечения и выздоровела ли женщина.
Врачи выполняют пациентам посев на молочницу довольно часто. При этом не все больные знают, что это за исследование.
Методика позволяет диагностировать кандидоз или, как еще называется это заболевание, молочницу. Патология считается довольно распространенной, что и объясняет популярность диагностического подхода.
Что это за грибок – кандида, интересуются больные у своих докторов, и как берут посев молочницу у представителей разных полов.
Какой врач может направить на исследование, и как пройти подготовку к нему?
- Кандида: что это за грибок
- Когда назначают бакпосев на кандиду
- Особенности посева на молочницу
- Правила подготовки к посеву на кандиду
- Как и откуда берется материал для посева на молочницу
- Какой доктор порекомендует посев на молочницу
- Расшифровка результатов посева
- Посев на молочницу: цена исследования и где его сделать
Кандида: что это за грибок
Прежде чем узнавать, что такое посев молочницы, необходимо понять, что это вообще за микроорганизм.
Кандида – это не бактерия и не вирус, вопреки распространенному мнению. Это грибок, который относится к группе условно-патогенных микроорганизмов.
Услышав об условной патогенности, пациенты склонны пугаться. На самом деле ничего страшного нет.
Условная патогенность характерна для большого числа микроорганизмов. Под этим термином кроется способность бактерий и грибков нормально существовать в человеческом организме. А при определенных обстоятельствах они провоцируют различные болезни. Так, например, кандидоз часто активизируется, если:
у пациента резко снизился иммунитет из-за другого инфекционного процесса в организме;
- произошел контакт со слишком холодной или очень горячей температурой;
- пришлось пропить долгий курс антибиотиков;
- у женщин молочница активизируется, как ответ на использование некоторых свечей вагинального типа;
- нарушение микрофлоры влагалища под влиянием самых разных факторов может привести к появлению симптомов и др.
Кандидоз не всегда требует немедленного лечения. Решают вопрос о необходимости терапии, исходя из состояния пациента и симптоматики.
Важно помнить о том, что инфекцией можно заразиться не только половым путем. Да и размножаться она может не только на слизистых оболочках гениталий.
Кандида – грибок, который легко живет в прямой кишке, а также в ротовой полости. Следовательно, помимо классических сексуальных контактов весомую опасность в плане заражения представляют нестандартные варианты секса. Также нельзя забывать о том, что кандида может передаваться от больного к здоровому через бытовые предметы. Грибок хорошо выживает на влажных полотенцах, мочалках, зубных щетках и других подобных предметах.
Когда назначают бакпосев на кандиду
Далеко не всем людям и не всегда назначают анализ. Чтобы порекомендовать человеку прохождение исследования, необходимы серьезные основания.
Показания к посеву молочницы – это, в первую очередь, появление симптомов болезни.
- чувство зуда, жжения в области гениталий, которое тяжело поддается коррекции или вовсе никак не уменьшается при использовании противозудных медикаментов;
- появление на кожных покровах высыпаний, которые сначала напоминают пузырьки, затем могут превращаться в красные пятнышки, доставляющие значительный дискомфорт;
- отечность области гениталий, а в особенности полового члена у представителей сильного пола и вульвы, половых губ у женщин;
- жалобы на появление специфических белесых выделений, запах которых напоминает скисшее молоко;
- на слизистых оболочках может обнаруживаться белая пленка, которую не получается легко отделить от поверхности кожи;
- появляются жалобы на дискомфорт, болезненность процесса мочеиспускания, в ряде случаев возможны жалобы на учащенные позывы к посещению туалета;
- у девушек перед месячными может появляться нехарактерная ранее болезненность.
Не только симптомы болезни, как отмечают доктора, могут стать поводом для того, чтобы пройти анализы. Также исследование рекомендуется во время профилактических осмотров. Оно позволяет понять, в каком состоянии находятся половые органы.
Оба половых партнера должны пройти анализ в том случае, если планируют завести ребенка в ближайшее время. При этом важно понимать, что сам по себе кандидоз угрозы беременности не несет. Но он способен активизироваться в период вынашивания ребенка у женщины и доставлять ей неудобства. Чтобы этого избежать, принимают ряд профилактических мероприятий.
Особенности посева на молочницу
Бак посев молочницы – достаточно известное исследование. Часто назначается пациентам при подозрении на активизацию этого условно-патогенного грибка. Далеко не все больные знают, в чем суть подобной диагностики.

Правила подготовки к посеву на кандиду
Посев на грибы рода кандида может показаться очень простым исследованием. В нем на самом деле нет ничего сложного. Но женщине или мужчине все же придется пройти элементарную подготовку перед тем, как у них будет собран биологический материал. Если подготовкой пренебречь, то результаты могут получиться сомнительными, о чем всегда предупреждают доктора.
Чтобы итогам исследования можно было верить, необходимо:
- минимум на 24 часа полностью исключить сексуальные связи, способные влиять на микрофлору половых органов;
- отказаться от жирной, жареной и другой вредной пищи минимум на несколько дней;
- не облегчать мочевой пузырь в течение 2-3 часов до сдачи анализа;
- отказаться от подмываний с использованием косметических средств накануне вечером, ограничившись применением простой проточной воды;
- исключить как минимум на сутки применение свечей вагинального типа и спринцеваний у женщин, промываний с помощью инстилляций у мужчин.
Часто звучит вопрос о том, когда можно после антибиотиков брать посев молочницу. В среднем промежуток между последним приемом препарата и забором биоматериала должен составлять не менее 7 дней. В некоторых случаях возможно сокращение сроков.
Важно помнить, что степень эффективности посева во многом зависит от того, насколько тщательно пациент будет соблюдать врачебные советы. Игнорирование базовых подготовительных правил приведет к неточным результатам. В итоге доктор может назначить неверное лечение, или пациенту придется сдавать образцы для исследования повторно.
Как и откуда берется материал для посева на молочницу
Посев на кандиду ассоциируется у всех больных, обращающихся к докторам, с забором биоматериала из половых путей. В большинстве случаев образцы на самом деле берутся с урогенитальной зоны.
Для женщин это исследование очень простое. По сути, оно не отличается от стандартного мазка и не причиняет неудобств. Процедура выполняется на гинекологическом кресле.
Медицинский работник собирает материал с уретры, из влагалища, а также с области маточной шейки. Какая-либо болезненность полностью отсутствует. Мужчины часто переносят исследование сложнее, так как их уретра расположена менее доступно. Требуется использование специальной трубки, через которую в уретру введут приспособление, берущее мазок. Это неприятно, в ряде случаев болезненно.
Дискомфорт может ощущаться в течение суток после процедуры, а иногда и более. Посев молочницу из ануса также могут брать. Делается это в том случае, если есть признаки поражения слизистых оболочек прямой кишки.
Характерные жалобы – это неприятные ощущения при дефекации, зуд, болезненность в анальной области, белесые выделения.
Посев на молочницу изо рта – еще один вариант получения биоматериала. Является самым простым. Однако выполняется только в том случае, если есть признаки вовлечения в патологический процесс ротоглотки.
Какой доктор порекомендует посев на молочницу
Нередко больные интересуются вопросом о том, от какого врача можно получить направление на посев на молочницу. Вариантов несколько.

Дерматовенеролог также принимает решение о необходимости назначения лечения, подбирает адекватную терапию.
В некоторых случаях рекомендацию можно получить от хирурга. Происходит это в том случае, если в области гениталий планируется оперативное вмешательство, а доктор отметил симптомы кандидоза в этой области.
Назначить посев могут также уролог или гинеколог. Оба специалиста работают с проблемами урогенитальной зоны. К ним на прием может попасть пациент с характерными для кандидоза жалобами.
Важно помнить, что перенаправление от уролога или гинеколога к дерматовенерологу не обязательно. Так как врачи этих специальностей также могут заниматься лечением кандидоза.
При поражении ротоглотки больше вероятность получить рекомендацию по прохождению посева от ЛОРа.
При вовлечении анальной зоны направление может дать проктолог.
Расшифровка результатов посева
Интерпретация посева молочницы должна выполняться врачом, который порекомендовал своему пациенту прохождение анализа. Самостоятельно делать выводы о наличии или отсутствии заболевания категорически запрещено. Так как высока вероятность неправильно поставить самому себе диагноз. Результаты могут быть:
В мазке полностью отсутствует патогенный микроорганизм. Симптоматика, если она есть, вызвана какой-либо другой патогенной бактерией или грибком.
В посеве может обнаруживать содержание грибков менее или равное 10 в 3 степени КОЕ/мл. Если при подобном содержании симптомы болезни отсутствуют, и пациент в целом чувствует себя хорошо, никакое лечение не показано. Результат считается удовлетворительным.
О положительном посеве говорится в том случае, если у человека есть явные признаки болезни и грибок в посеве. Также положительным результат может быть, если симптоматика отсутствует, но количество патогенов превышает отметку в 10 в 3 степени. В этом случае необходимо задуматься о выборе лечения.
Посев на молочницу: цена исследования и где его сделать
Вопрос о том, где сделать посев на молочницу, стоять не должен.
Обратиться можно как в КВД, где легко выполняется это исследование, так как считается недорогим. Так и в частную диагностическую лабораторию. Поскольку вероятность влияния на результаты человеческого фактора минимальна, разница между частным центром и государственным учреждением не слишком заметна.
Цена посева на молочницу может сильно варьироваться. Все зависит от самой клиники, квалификации врача, сопутствующих исследований, которые планируется выполнить. В среднем стоимость варьируется от 1000 до 1800 рублей за один анализ. Естественно, пересдача анализа в случае сомнительных результатов оплачивается отдельно.
Кандидоз – заболевание, столкнуться с которым в течение жизни может любой человек. Из-за условной патогенности бактерия широко распространена в человеческой популярности. Способствовать обострению симптомов может любое негативное воздействие на организм извне.
При появлении симптомов выполняется посев на этот патогенный грибок, и по его результатам доктор рекомендует подходящее лечение!

у пациента резко снизился иммунитет из-за другого инфекционного процесса в организме;
